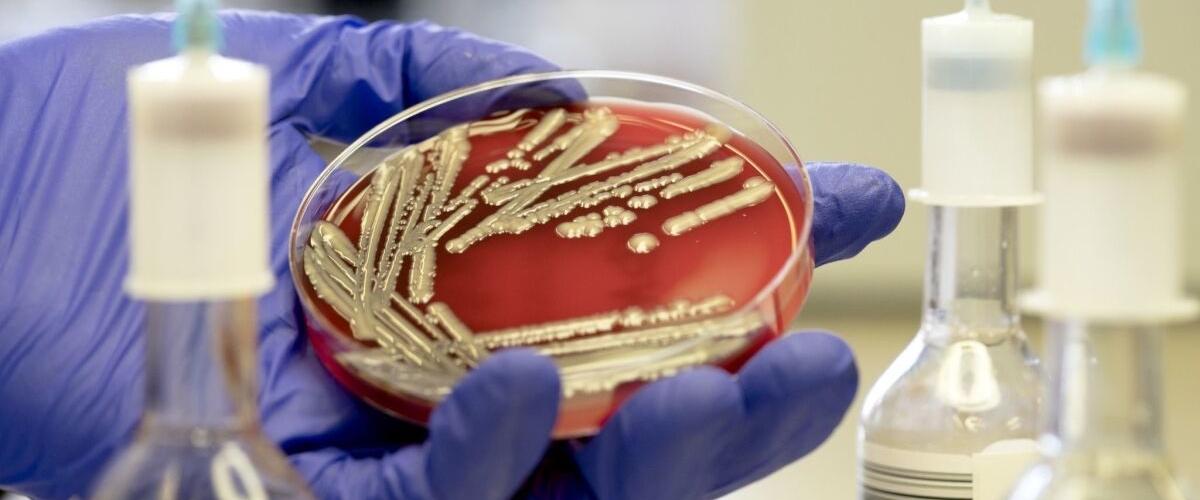
TODO:

Резистентность бактерий к антибиотикам относится к одной из главных глобальных угроз здоровью человека, поэтому ученые находятся в непрерывной гонке в создании новых препаратов против супербактерий. Ученые из США решили пойти более простым путем, чтобы выяснить, можно ли использовать существующие сегодня препараты, доступные почти в каждой в аптеке, против устойчивых бактерий.
В рамках исследования они проанализировали более 500 комбинаций антибиотиков и бактерий и выяснили, что в 15% случаев стандартный тест на чувствительность к лекарствам ошибается.
С точки зрения практической медицины это огромный показатель, поскольку сегодня врачи помимо собственного опыта полагаются исключительно на этот тест для принятия решения о схеме лечения для конкретного пациента.
Результаты привели к созданию нового теста на чувствительность DMEM, использующее иную культуральную среду. Его главное отличие в том, что он учитывает влияние организма на эффективность лекарства.
«Люди — это не чашка Петри, поэтому, работающие в культуре клеток бактерии могут не сработать в организме. Тестирование препаратов в условиях, имитирующих тело, повышает точность, по которой можно судить об эффективности», — заявил соавтор работы Майкл Махан. По его словам, переоценка эффективности уже существующих антибиотиков принесет большую пользу, чем затраты на разработку новых лекарств.
Между тем другие ученые продолжают работу над созданием новых препаратов против супербактерий. Например, создан меняющий форму препарат, запутывающий бактерий, а также антибиотик на основе золота.